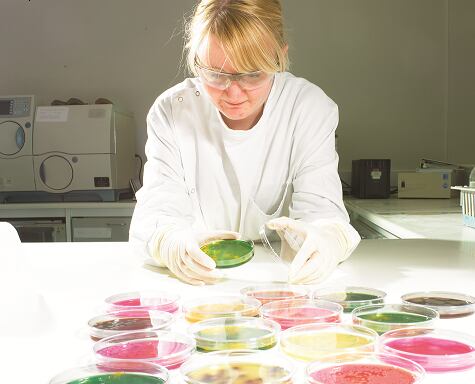

The research firm said it was ‘very concerning’ that members reported the level of practical experience of some microbiologists, technologists and managers was not sufficient to meet the changing needs of the food and drink sector.
A report has been published aimed at tackling the shortfall in the required practical skills and knowledge of employees in the industry.
Tesco, Sainsbury’s, Marks and Spencer, Tulip, Greencore and 2 Sisters Food Group were among more than 20 firms who contributed to the report.
A member meeting is being held today to track the development of microbiological training.
Industry concerns
Bertrand Emond, head of membership and training at Campden BRI, said the document comes at a time when pathogenic organisms are a great threat and product spoilage continues to contribute to food wastage and financial loss.
“To form the document we sat down with industry and tried to put in order their concerns which were wide-ranging,” he told FoodQualityNews.com.
“Coming out of the discussions were a number of factors, one was that people are retiring and we are losing their experience out of the business, another is that experienced and competent people are being promoted in senior positions so they are not using their experience in the day to day.
“The third point is new graduates from some universities lack the right skills and practical understanding and the fourth bit is there didn’t seem to be the right courses out there to train people in terms of format and content.”
Differing training
The report recognises microbiological training needs differ depending on job roles, for example, training requirements of laboratory staff are not the same as food technologists.
Acknowledging differences and tailoring microbiological training to sector specific needs is much more effective than a ‘one size fits all’ approach, said Campden BRI.
Emond said the strength and weaknesses of new technology need to be evaluated as something may be quicker but it needs to be done properly to avoid false negatives and false positives.
He said it was the first report that captures industry needs in the area.
“It can be used for universities to form their course and subjects and as part of Campden BRI’s aim to improve professional development. It is for people to keep up to date with new developments in the industry.”
Skill base eroded
Gayna Quinn, group technical director at Tulip, said the skills gap represents a potential food safety risk for industry.
“With many experienced food and drink microbiologists either leaving or retiring from the industry, or their roles expanding to include additional areas of responsibility, there is a real concern that much of the applied industrial microbiological skills base is being eroded.”
She said new staff coming into the industry often lack the appropriate knowledge and practical skills.
“Food industry requirements are constantly evolving – changes in the use and storage of food materials, together with global sourcing and the impact of climate change mitigation are all placing additional challenges on the control of microbiological risks in the global food and drink supply chain.
“This means that now, more than ever before, we need to invest in microbiological training to up-skill existing employees and lay the foundations of good working practice for the next generation.”
Four key training themes were identified: building safety in, understanding microbiology, practical microbiology and when things go wrong.
The report will be used by Campden BRI to develop training and related continuing professional development (CPD) for industry.
Margaret McPheat, head of technical services at Greencore, added: “The sector relies upon the skills of its workforce to develop and manufacture high quality, authentic products that are safe for consumers.
“Focused, specialist microbiological training that equips staff to do their jobs across the diverse range of roles within food manufacture and retailing is not a ‘nice to have’; it is absolutely essential.”